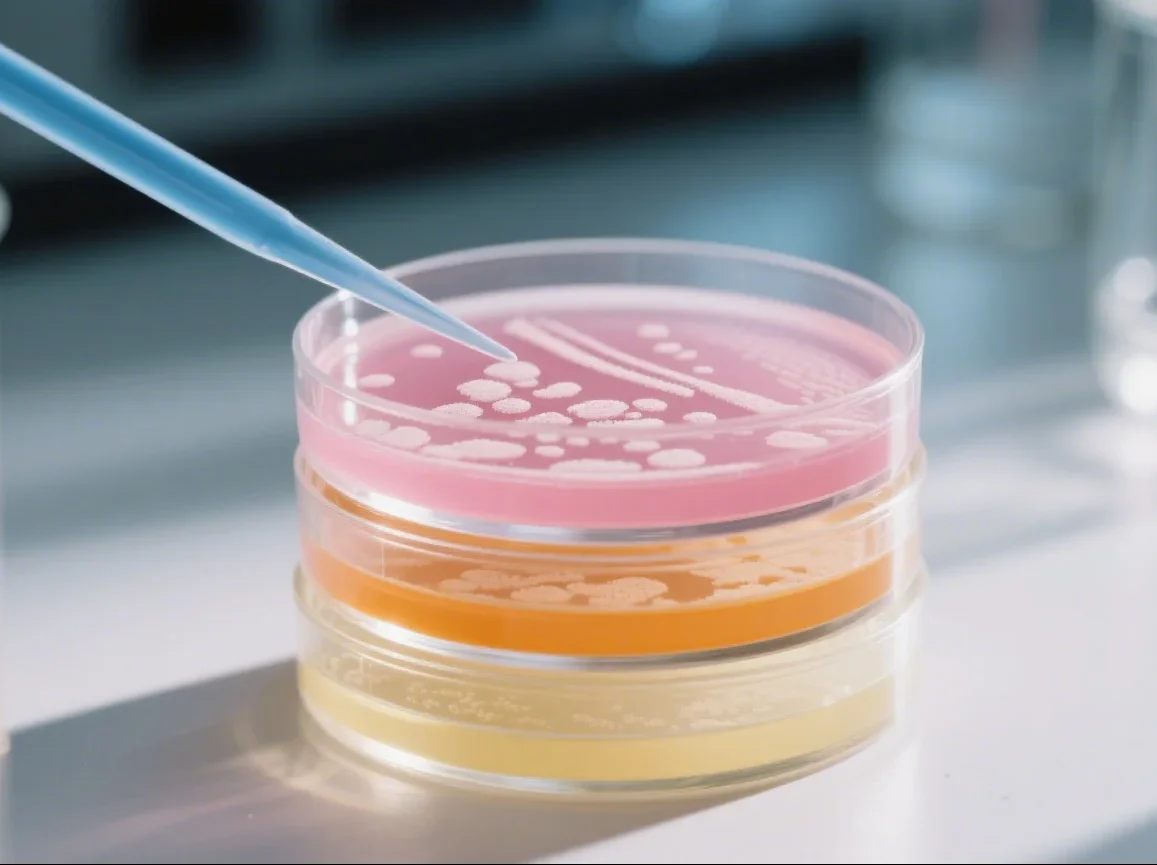
Preventing Culture Medium Contamination: Key Principles for Reliable Laboratory Testing
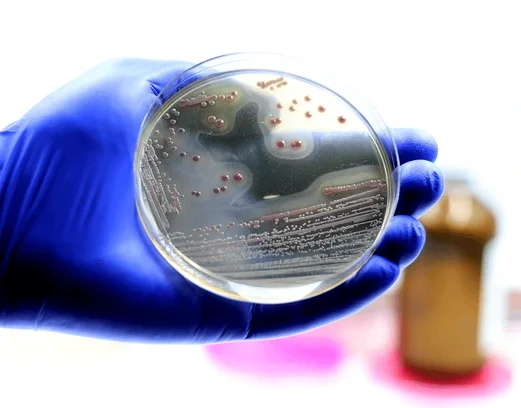
Chromogenic Culture Media: Decoding the “Secret Language” of Microorganisms with Color
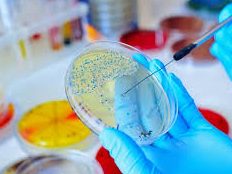
Internal Quality Control of Aseptic Rooms in Food Microbiology Labs

Glutamine in Cell Culture
News 14 10 月, 2025
L-Glutamine, a coded amino acid in protein synthesis, is a common serum-free culture medium supplement used to support the proliferation and physiological functions of various mammalian cells. In commonly used culture media, glutamine concentrations range from 0.5 mM in Ames medium to 10 mM in MCDB 131 medium, typically between 2–4 mM. Primary Funct…
Causes and Solutions for Cell Vacuolization
News 14 10 月, 2025
During cell culture, researchers may occasionally observe vacuoles forming within cells. Vacuoles are bubble-like structures in the cytoplasm that differ in appearance from the surrounding cell content. This article explains the main causes of cell vacuolization and provides guidance on how to prevent and resolve the issue. Definition Cell vacuolizat…
Preventing and Handling Black Dots in Cell Culture
News 14 10 月, 2025
When culturing cells, many researchers notice small black dots under the microscope and wonder — are they cell debris or contamination? How to Identify the Cause 1. Observe movement:Particles showing slow Brownian motion are usually harmless cell debris, while rapidly moving dots may indicate bacterial contamination. 2. Check the medium:Contaminat…
Key Principles of Aseptic Filling Monitoring in Cleanrooms
News 8 9 月, 2025
In sterile pharmaceutical manufacturing, aseptic filling is one of the most critical processes. Since injectable drugs bypass the body’s natural immune defenses, even the smallest contamination during filling can put patients at risk. To ensure safety, manufacturers must operate in cleanrooms that meet the strictest global standards and maintain rigorous m…
Preventing Culture Medium Contamination: Key Principles for Reliable Laboratory Testing
News 8 9 月, 2025
In clinical diagnostics, vaccine development, biopharmaceuticals, and biomedical research, culture media serve as the foundation for microbial isolation, antibiotic susceptibility testing, cell modeling, and pathogenicity studies. The quality of culture media directly affects pathogen detection, experimental accuracy, and production safety. Even a single f…
Microbial Detection in Food Safety: Plate Count Method vs. Flow Cytometry
News 18 8 月, 2025
Food safety relies heavily on microbial detection, which plays a critical role in assessing contamination levels, identifying hazards, and ensuring compliance with testing requirements. Selecting the right detection method depends on the type of microorganism, the food matrix, and the goals of the analysis. Among various approaches—including traditional…
Chromogenic Culture Media: Decoding the “Secret Language” of Microorganisms with Color
News 18 8 月, 2025
Principle of Chromogenic Culture Media Chromogenic culture media enable precise microbial identification through enzyme-substrate reactions. When microorganisms grow on the medium, specific enzymes interact with chromogenic substrates—composed of a chromophore and a metabolizable component. This reaction releases a colored compound, making colonies visi…
Pseudomonas aeruginosa ATCC 27853: A Standard Strain for Microbiology Research and Quality Control
News 18 8 月, 2025
IntroductionPseudomonas aeruginosa ATCC 27853 is a widely used reference strain in microbiology, applied in scientific research, quality control, and education. Due to its well-defined characteristics, it is one of the most important strains for studying bacterial physiology, antibiotic susceptibility, and environmental detection. 1. Basic Informati…
HCM072 Cooked Meat Medium Base
Dehydrated Culture Media, News 4 8 月, 2025
Product No.Product CategorySpecificationHCM072Dehydrated Culture Medium500g/bottle Intended Use For the primary growth and maintenance of aerobic and anaerobic organisms. Principle and Interpretation Proteose peptone provide carbon and nitrogen sources, vitamins, and growth factors; Dextrose is the carbon source which can be used as an energy s…
HCM006 Violet Red Bile Glucose Agar
Dehydrated Culture Media, News, Product 4 8 月, 2025
For detection and enumeration of Enterobacteriaceae. Principle and Interpretation Gelatin peptone and yeast extract provide nitrogenous, carbonaceous compounds, long chain amino acids, vitamins and other nutrients essential for bacterial metabolism. This media is selective due to presence of the inhibitors; bile salts positive organisms especially St…
Preparation of Competent E. coli Cells and Plasmid Transformation
News 16 7 月, 2025
Competent Escherichia coli (E. coli) cells are host cells made receptive to foreign DNA by calcium chloride (CaCl₂) treatment, which temporarily increases cell membrane permeability. This process enables efficient plasmid transformation. 1. What Are Competent Cells? Competence is a physiological state that allows cells to uptake and incorporate …
Internal Quality Control of Aseptic Rooms in Food Microbiology Labs
News 16 7 月, 2025
The aseptic room is the cornerstone for testing bacteria, yeast, mold, and various pathogenic microorganisms in food microbiology. Whether it meets sterile operational standards and has a sound internal quality control system directly impacts the accuracy of microbiological testing results. 1. Layout and Design of the Aseptic Room The walls, floo…